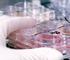
Ergebnisse Praktikum-Mikrobiologie Mikrobiologische Wasseruntersuchungen

RIDA GENE ETEC/EIEC real-time PCR
|
|
|
- Robert Althaus
- vor 8 Jahren
- Abrufe
Transkript
1 RIDA GENE ETEC/EIEC real-time PCR Art. Nr.: PG Reaktionen Für die in-vitro Diagnostik. -20 C R-Biopharm AG, An der neuen Bergstraße 17, D Darmstadt, Germany Tel.: +49 (0) / Telefax: +49 (0)
2 1. Verwendungszweck Für die in-vitro Diagnostik. RIDA GENE ETEC/EIEC ist eine multiplex real-time PCR zum direkten qualitativen Nachweis und zur Differenzierung der Pathogenitätsfaktor- Gene von ETEC und EIEC/Shigella spp. in humanen Stuhl- und Kulturproben. 1,2 Die RIDA GENE ETEC/EIEC multiplex real-time PCR soll die Diagnose einer durch pathogene Escherichia coli bzw. Shigella spp. verursachte Gastroenteritis unterstützen. 2. Erläuterung Escherichia coli (E. coli) sind gram-negative, durch peritriche Begeißelung bewegliche, fakultativ anaerobe Stäbchenbakterien und gehören zur Familie der Enterobacteriaceae. E. coli ist Bestandteil der normalen Darmflora des Menschen, aber auch vieler landwirtschaftlicher Nutztiere und ist in der Regel apathogen. Einige Stämme von E. coli sind durch den Erwerb von bestimmten Pathogenitätsfaktoren (z.b. Toxin-Gene) humanpathogen. Die sechs bekannten darmpathogenen E. coli, enterohämorrhagische E. coli (EHEC), enteropathogene E. coli (EPEC), enterotoxische E. coli (ETEC), enteroinvasive E. coli (EIEC), enteroaggregative E. coli (EAEC) und diffus adhärente E. coli (DAEC) lassen sich durch die spezifischen Pathogenitätsfaktoren differenzieren. 1 Eine besondere Bedeutung unter den darmpathogenen E. coli haben die enterotoxischen E. coli (ETEC) erlangt. ETEC sind häufigster Erreger von Reisediarrhoe bei Reisenden in Entwicklungsländern (30-60% der Fälle). Aber auch bei 11-16% der Reiserückkehrer verursachen ETEC Reisediarrhoe. In Entwicklungsländern erkranken jedes Jahr durch ETEC ca. 210 Millionen Kinder an Diarrhoe und ca Kinder sterben daran. 2 ETEC besitzen zwei wichtige Pathogenitätsfaktoren. Sie sind in der Lage, entweder ein hitzstabiles (ST) und/oder ein hitzlabiles (LT) Enterotoxin zu bilden. Klinische Symptome sind milde bis akute, reiswasserartige Durchfälle, die oft innerhalb weniger Tage ohne spezifische Therapie abklingen. Lebensbedrohliche Fälle der ETEC Diarrhoe treten meist bei Säuglingen in Entwicklungsländern auf. Infektionsquellen sind hauptsächlich kontaminiertes Wasser und Nahrungsmittel. Infektionsketten von Mensch zu Mensch können bislang ausgeschlossen werden. Enteroinvasive E. coli (EIEC) verursachen in Entwicklungsländern, aber auch bei Reisenden in diese Länder eine Shigellose-ähnliche Erkrankung, da sie biochemisch und genetisch sehr eng mit Shigella spp. verwandt sind. Die Pathogenität von EIEC und auch Shigella spp. beruht auf der plasmidvermittelten Fähigkeit in Colonepithelzellen einzudringen und diese zu zerstören. 3 2 RIDA GENE ETEC/EIEC
3 Durch den Nachweis des ipah Gens (invasion plasmid antigen H Gen) können EIEC/Shigella spp. gegen ETEC abgegrenzt werden. Die klinischen Symptome der durch EIEC verursachten Shigellose sind charakterisiert durch anhaltende Bauchkrämpfe mit wässrigem, eventuell blutigem Durchfall. Infektionsquellen sind hauptsächlich kontaminiertes Wasser und Nahrungsmittel, aber auch Infektionsketten von Mensch zu Mensch sind von Bedeutung Testprinzip RIDA GENE ETEC/EIEC ist eine multiplex real-time PCR zum direkten qualitativen Nachweis und zur Differenzierung der Pathogenitätsfaktor-Gene von ETEC und EIEC/Shigella spp. Nach der DNA-Isolierung werden (falls vorhanden) die spezifischen Genfragemente des hitzelabilen Enterotoxins LT (elt), des hitzestabilen Enterotoxins ST (esta) und das ipah Gen amplifiziert. Die amplifizierten Zielsequenzen werden mit Hydrolyse-Sonden, die an einem Ende mit dem Quencher und am anderen Ende mit einem Reporter-Fluoreszenzfarbstoff (Fluorophor) markiert sind, nachgewiesen. In Gegenwart einer Zielsequenz hybridisieren die Sonden mit den Amplikons. Während der Extension trennt die Taq-Polymerase den Reporter vom Quencher. Der Reporter emittiert ein Fluoreszenzsignal, das durch die optische Einheit eines real-time PCR-Gerätes detektiert wird. Das Fluoreszenzsignal steigt mit der Menge der gebildeten Amplikons an. Der RIDA GENE ETEC/EIEC Test enthält eine Internal Control DNA (ICD), um die Probenpräparation und/oder eine potentielle PCR Inhibition kontrollieren zu können. RIDA GENE ETEC/EIEC
4 4. Packungsinhalt Tab.1: Packungsinhalt (Die Reagenzien einer Packung reichen für 100 Bestimmungen) Kit Code Reagenz Menge Deckelfarbe 1 Reaction Mix 2x 1100 µl gelb 2 Taq-Polymerase 1x 11 µl rot D Internal Control DNA 2x 1800 µl orange N PCR Water 1x 500 µl weiß P Positive Control 1x 200 µl blau 5. Reagenzien und ihre Lagerung - Alle Reagenzien müssen lichtgeschützt bei -20 C gelagert werden und können bis zum aufgedruckten Verfallsdatum verwendet werden. Nach Erreichen des Verfallsdatums kann keine Qualitätsgarantie mehr übernommen werden. - Vor dem Gebrauch sollten die Reagenzien schonend aufgetaut werden (z.b. im Kühlschrank bei 2-8 C). - Ein wiederholtes Einfrieren/Auftauen bis zu 5 Mal beeinträchtigt die Testeigenschaft nicht (ggf. Aliquots nach dem ersten Auftauen herstellen und die Reagenzien sofort wieder einfrieren). - Alle Reagenzien während der PCR-Vorbereitung geeignet kühlen (2-8 C). 4 RIDA GENE ETEC/EIEC
5 6. Zusätzlich benötigte Geräte und Materialien - DNA-Extraktionskit für Stuhlproben (z.b. RTP Pathogen Kit, STRATEC Molecular) oder - DNA-Extraktionsysteme für Stuhlproben (z.b. Maxwell 16 (Promega), NucliSENS easy MAG (biomérieux)) - Real-time PCR-Gerät: Roche: LightCycler 480II Cepheid: SmartCycler Applied Biosystems: ABI 7500 Abbott: m2000rt Stratagene: Mx3000P, Mx3005P QIAGEN: Rotor-Gene Q - RIDA GENE ColorCompensation Kit I (PG0001) bei Verwendung des LightCycler 480II (Roche) - Real-time PCR Verbrauchsmaterialien (Platten, Reaktionsgefäße, Folien) - Zentrifuge mit Rotor für Reaktionsgefäße, Platten - Vortexer - Pipetten (0,5 20 µl, µl, µl) - Pipettenspitzen mit Filtern - Puderfreie Einmalhandschuhe 7. Vorsichtsmaßnahmen - Nur für die in-vitro Diagnostik. - Eine räumliche Trennung von Extraktion, PCR-Ansatz und PCR ist zu beachten, um Querkontaminationen zu vermeiden. - Dieser Test ist nur von molekularbiologisch geschultem Laborpersonal durchzuführen. - Die Gebrauchsanweisung zur Durchführung des Tests ist strikt einzuhalten. - Während des Umgangs mit Proben Einmalhandschuhe tragen und nach Abschluss des Tests die Hände waschen. - In den Bereichen, in denen mit Proben gearbeitet wird, nicht rauchen, essen oder trinken. - Klinische Proben müssen als potentiell infektiös angesehen werden und müssen wie sämtliche Reagenzien und Materialien, die mit potentiell infektiösen Proben zusammenkommen, entsprechend entsorgt werden. - Testkit nach Erreichen des Verfallsdatums nicht mehr verwenden. RIDA GENE ETEC/EIEC
6 8. Testdurchführung 8.1 Probenvorbereitung DNA-Isolierung aus Stuhlproben Für die DNA-Isolierung aus Stuhlproben wird ein kommerziell erhältliches DNA-Isolierungskit (z.b. RTP Pathogen Kit (STRATEC Molecular)) oder DNA-Extraktionsystem (z.b. Maxwell 16 (Promega)) empfohlen. Die Angaben des Herstellers sind zu beachten. Es wird empfohlen die Stuhlproben vor der Extraktion 1:3 mit Wasser zu verdünnen, stark zu vortexen und 30 sec bei rpm zu zentrifugieren. Aus dem Überstand das entsprechende Volumen nach Angaben des Herstellers verwenden. Der RIDA GENE ETEC/EIEC Test enthält eine Internal Control DNA (ICD), die entweder nur als Inhibitionskontrolle oder als Extraktionskontrolle für die Probenpräparation und Inhibitionskontrolle verwendet werden kann. Wird die Internal Control DNA (ICD) nur als Inhibitionskontrolle verwendet, muss 1 µl der ICD dem Master-Mix hinzugefügt werden (s. Tab.3). Wird die Internal Control DNA (ICD) als Extraktionskontrolle für die Probenpräparation und als Inhibitionskontrolle verwendet, müssen 20 µl der ICD während der Extraktion eingesetzt werden. Die ICD soll dem Proben-Lysispuffer Mix und nicht direkt dem Probenmaterial zugefügt werden DNA-Isolierung aus Kulturproben Für die DNA-Isolierung aus Kulturproben wird folgende Isolierungssmethode empfohlen: In ein Präparationsröhrchen 1 ml A. dest (DNAse frei) geben. Mit einer Impföse mehrere Kolonien sammeln und im A. dest (DNAse frei) suspendieren. Den Stab der Impföse abbrechen oder abschneiden. Das Präparationsröhrchen dicht verschließen und 60 Sekunden stark vortexen. Danach im Heizblock für 10 Minuten bei 95 C unter Schütteln erhitzen. Anschließend bei rpm 1 min zentrifugieren und den Überstand als Probe einsetzen. Hinweis: Bei starker Trübung den Zentrifugationsschritt ggf. wiederholen. Der RIDA GENE ETEC/EIEC Test enthält eine Internal Control DNA (ICD), die entweder nur als Inhibitionskontrolle oder als Extraktionskontrolle für die Probenpräparation und Inhibitionskontrolle verwendet werden kann. Wird die Internal Control DNA (ICD) nur als Inhibitionskontrolle verwendet, muss 1 µl der ICD dem Master-Mix hinzugefügt werden (s. Tab.3). 6 RIDA GENE ETEC/EIEC
7 Wird die Internal Control DNA (ICD) als Extraktionskontrolle für die Probenpräparation und als Inhibitionskontrolle verwendet, müssen 20 µl der ICD während der DNA-Isolierung eingesetzt werden. Die ICD soll dem Proben-A.dest Mix und nicht direkt dem Probenmaterial zugefügt werden. 8.2 Herstellung des Master-Mix Die Gesamtzahl der für die PCR benötigten Reaktionen (Proben und Kontrollreaktionen) ist zu berechnen. Bei jedem Testlauf muss eine Positiv- und eine Negativkontrolle mitgeführt werden. Es wird empfohlen den Master-Mix mit 10 % zusätzlichem Volumen anzusetzen, um einen Pipettierverlust auszugleichen (s. Tab.2, Tab.3). Vor der Benutzung den Reaction Mix, die Taq-Polymerase, die Positive Control, das PCR Water und die ICD auftauen, durchmischen und kurz zentrifugieren. Reagenzien während der Arbeitsschritte stets geeignet kühlen (2 8 C). Tab.2: Beispiel für die Berechnung und Herstellung des Master-Mix für 10 Reaktionen (ICD als Extraktions- und Inhibitionskontrolle) Kit Code Komponenten des Master-Mix Menge pro Reaktion 10 Reaktionen (zusätzlich 10 %) 1 Reaction Mix 19,9 µl 218,9 µl 2 Taq-Polymerase 0,1 µl 1,1 µl Gesamt 20 µl 220 µl Master-Mix mischen und anschließend kurz abzentrifugieren. Tab.3: Beispiel für die Berechnung und Herstellung des Master-Mix für 10 Reaktionen (ICD nur als Inhibitionskontrolle) Kit Code Komponenten des Master-Mix Menge pro Reaktion 10 Reaktionen (zusätzlich 10 %) 1 Reaction Mix 19,9 µl 218,9 µl 2 Taq-Polymerase 0,1 µl 1,1 µl D Internal Control DNA 1,0 µl 11 µl Gesamt 21,0 µl 231,0 µl Master-Mix mischen und anschließend kurz abzentrifugieren. RIDA GENE ETEC/EIEC
8 8.3 Herstellung des PCR-Mix Je 20 µl des Master-Mix in die jeweiligen Reaktionsgefäße (Gefäße/Platten) pipettieren. Negativkontrolle: Je 5 µl PCR Water zum vorgelegten Master-Mix als Negativkontrolle pipettieren. Hinweis: Wir empfehlen bei Verwendung der ICD als Extraktionskontrolle für die Probenpräparation und die Inhibitionskontrolle je 1 µl der ICD zum PCR-Mix der Negativkontrolle zu pipettieren. Proben: Positivkontrolle: Je 5 µl DNA-Extrakt zum vorgelegten Master-Mix der Probenreaktionen pipettieren. Je 5 µl Positive Control zum vorgelegten Master-Mix in die dafür vorgesehenen Reaktionsgefäße pipettieren. Hinweis: Wir empfehlen bei Verwendung der ICD als Extraktionskontrolle für die Probenpräparation und die Inhibitionskontrolle je 1 µl der ICD zum PCR-Mix der Positivkontrolle zu pipettieren. Reaktionsgefäße bzw. Platte verschließen, mit wenigen Umdrehungen pro Minute kurz abzentrifugieren und in das real-time PCR-Gerät überführen. Die PCR entsprechend der Geräteeinstellung starten (s. Tab.4, Tab.5). 8 RIDA GENE ETEC/EIEC
9 8.4 Geräteeinstellungen Tab.4: Real-time PCR Profil für LightCycler 480II, SmartCycler und Rotor-Gene Q Initiale Denaturierung 1 min, 95 C Zyklen PCR Denaturierung Annealing / Extension 45 Zyklen 10 sec, 95 C 15 sec, 60 C Temperature Transition Rate / Ramp Rate Maximum Bemerkung: Das Annealing und die Extension finden im selben Schritt statt. Tab.5: Real-time PCR Profil für Mx3000P, Mx3005P, ABI7500 und m2000rt Initiale Denaturierung 1 min, 95 C Zyklen PCR Denaturierung Annealing / Extension 45 Zyklen 15 sec, 95 C 30 sec, 60 C Temperature Transition Rate / Ramp Rate Maximum Bemerkung: Das Annealing und die Extension finden im selben Schritt statt. Hinweis: Bei Verwendung des SmartCycler (Cepheid) müssen die Man. Grenzwert Flour. Einheiten für Kanal 1 auf 30.0 und für Kanal 2 bis 4 auf 5.0 eingestellt werden. RIDA GENE ETEC/EIEC
10 8.5 Detektionskanaleinstellung Tab.6: Auswahl der geeigneten Detektionskanäle Real-time PCR Gerät Roche LightCycler 480II Nachweis Detektionskanal Dark- Quencher LT 465/510 + ICD 533/580 + ipah 533/610 + ST 618/660 + Bemerkung RIDA GENE Color Compensation Kit I (PG0001) wird benötigt Cepheid SmartCycler ABI 7500 Abbott m2000rt Stratagene Mx3000P/ Mx3005P Qiagen Rotor-Gene Q LT Kanal 1 + ICD Kanal 2 + ipah Kanal 3 + ST Kanal 4 + LT FAM none ICD VIC none ipah ROX none ST Cy5 none LT FAM none ICD VIC none ipah ROX none ST Cy5 none LT FAM + ICD HEX + ipah ROX + ST Cy5 + LT Green + ICD Yellow + ipah Orange + ST Red + Stellen Sie die Man. Grenzwert Flour. Einheiten für Kanal 1 auf 30.0 und für Kanal 2 bis 4 auf 5.0 ein Stellen Sie den passiven Referenzfarbstoff ROX auf none - Stellen Sie den Referenzfarbstoff auf none - 10 RIDA GENE ETEC/EIEC
11 9. Interpretation der Ergebnisse Die Auswertung der Proben erfolgt über die Analyse-Software des jeweiligen real-time PCR-Gerätes nach den Angaben des Herstellers. Negativ- und Positivkontrollen müssen die korrekten Ergebnisse zeigen (s. Abb.1, Abb.2, Abb.3). Die Positivkontrolle liegt in einer Konzentration von 10 3 Kopien / µl vor. Sie wird in einer Gesamtmenge von 5 x 10 3 Kopien in jedem PCR Lauf eingesetzt. Abb.1: Korrekter Verlauf der Positiv- und Negativkontrolle (LT Gen) auf dem LightCycler 480II RIDA GENE ETEC/EIEC
12 Abb.2: Korrekter Verlauf der Positiv- und Negativkontrolle (ST Gen) auf dem LightCycler 480II Abb.3: Korrekter Verlauf der Positiv- und Negativkontrolle (ipah Gen) auf dem LightCycler 480II 12 RIDA GENE ETEC/EIEC
13 Die Probenauswertung der Ergebnisse erfolgt nach Tabelle 7. Tab.7: Interpretation der Ergebnisse Pathogenitätsfaktor-Gene LT ST ipah ICD Ergebnis positiv positiv negativ positiv/negativ ETEC nachweisbar positiv negativ negativ positiv/negativ ETEC nachweisbar negativ positiv negativ positiv/negativ ETEC nachweisbar negativ negativ positiv positiv/negativ negativ negativ negativ positiv EIEC/Shigella spp. nachweisbar Zielgene sind nicht nachweisbar negativ negativ negativ negativ Ungültig ETEC und EIEC/Shigella spp. sind nachweisbar, wenn die Proben-DNA und die Internal Control DNA (ICD) eine Amplifikation im Nachweissystem zeigt. ETEC und EIEC/Shigella spp. sind ebenfalls nachweisbar, wenn die Proben-DNA eine Amplifikation, jedoch keine Amplifikation für die Internal Control DNA (ICD) im Nachweissystem zeigt. Der Nachweis der Internal Control DNA (ICD) ist in diesem Fall nicht notwendig, da hohe Konzentrationen des Amplikons zu einem schwachen oder fehlenden Signal der internen Amplifikationskontrolle führen können. ETEC und EIEC/Shigella spp. sind nicht nachweisbar, wenn die Proben-DNA keine Amplifikation, aber die Internal Control DNA (ICD) eine Amplifikation im Nachweissystem zeigt. Eine Inhibierung der PCR-Reaktion kann durch die Detektion der Internal Control DNA (ICD) ausgeschlossen werden. Eine Probe ist ungültig, wenn die Proben-DNA und die Internal Control DNA (ICD) im Nachweissystem keine Amplifikation zeigt. In der Probe sind PCR-Inhibitoren vorhanden bzw. es trat ein Fehler im Extraktionsverfahren auf. Die extrahierte Probe sollte 1:10 mit PCR Wasser verdünnt und erneut amplifiziert werden oder es sollte die Isolierung und Reinigung der Probe verbessert werden. RIDA GENE ETEC/EIEC
14 10. Testmerkmale 10.1 Analytische Sensitivität Die RIDA GENE ETEC/EIEC multiplex real-time PCR hat eine Nachweisgrenze von 5 DNA-Kopien / Reaktion für LT, ST und ipah Gen (s.abb.4, Abb.5, Abb.6). Abb.4: Verdünnungsreihe LT Gen ( DNA Kopien / µl) auf dem LightCycler 480II Abb.5: Verdünnungsreihe ST Gen ( DNA Kopien / µl) auf dem LightCycler 480II 14 RIDA GENE ETEC/EIEC
15 Abb.6: Verdünnungsreihe ipah Gen ( DNA Kopien / µl) dem LightCycler 480II Die Nachweisgrenze des Gesamtverfahrens ist abhängig von der Probenmatrix, der DNA-Extraktion und dem DNA-Gehalt Analytische Spezifität Die RIDA GENE ETEC/EIEC multiplex real-time PCR ist spezifisch für ETEC und EIEC/Shigella spp. Es wurden keine Kreuzreaktivitäten zu den folgenden Spezies festgestellt (s. Tab.8): Tab.8: Kreuzreaktivitätstestung Arcobacter butzleri - Aeromonas hydrophila - Bacillus cereus - Bacteroides fragilis - Campylobacter coli - Campylobacter jejuni - Candida albicans - Citrobacter freundii - Clostridium difficile - Clostridium perfringens Clostridium sordellii Enteropathogene E.coli Shigatoxin bildende E.coli Enterobacter cloacae Enterococcus faecalis Klebsiella oxytoca Proteus vulgaris - Pseudomonas aeruginosa - - Salmonella enteritidis - - Salmonella typhimurium - - Serratia liquefaciens - - Staphylococcus aureus - - Staphylococcus epidermidis - Vibrio parahaemolyticus - - Yersinia enterocolitica - - RIDA GENE ETEC/EIEC
16 11. Grenzen des Verfahrens 1. Das Ergebnis der molekularbiologischen Untersuchung sollte nicht allein zur Diagnose führen, sondern immer im Zusammenhang mit der Anamnese und Symptomatik des Patienten betrachtet werden. 2. Dieser Test ist nur für Stuhl- und Kulturproben validiert. 3. Unsachgemäße Probenentnahme, -transport, -lagerung und -handhabung oder eine Viruslast unterhalb der analytischen Sensitivität des Tests können zu falsch negativen Ergebnissen führen. 4. Die Anwesenheit von PCR-Inhibitoren kann zu nicht auswertbaren Ergebnissen führen. 5. Mutationen oder Polymorphismen in den Primer- oder Sondenbindungsregion können den Nachweis neuer oder unbekannter Varianten beeinträchtigen und mit RIDA GENE ETEC/EIEC zu falsch negativen Ergebnissen führen. 6. Wie bei allen auf PCR basierenden in-vitro-diagnostischen Tests können äußerst niedrige Konzentrationen der Zielsequenzen, die unter dem Detektionslimit (LoD) liegen, nachgewiesen werden. Die erhaltenen Ergebnisse sind nicht immer reproduzierbar. 7. Ein positives Testergebnis zeigt nicht notwendigerweise die Anwesenheit lebensfähiger Organismen an. Ein positives Ergebnis deutet darauf hin, dass die Zielgene (elt, esta oder ipah) vorhanden sind. 12. Literatur 1. Kaper JM, et al. PATHOGENIC ESCHERICHIA COLI. Nature Reviews Microbiology 2004; 2: Steffen R et al. Vaccination against enterotoxigenic Escherichia coli, a cause of travelers diarrhea. J Travel Med 2006; 12: Nataro JP and Kaper JM. Diarrheagenic Escherichia coli. Clinical Microbiology Reviews 1998; 11(1): Veira N et al. High Prevalence of Enteroinvasive Escherichia Coli isolated in a remote region of Nothern Coastal Ecuador. Am J Trop Med Hyg 2007, 76(3): RIDA GENE ETEC/EIEC
RIDA GENE Clostridium difficile HyperTox real-time PCR
 RIDA GENE Clostridium difficile HyperTox real-time PCR Art. Nr.: PG0855 50 Reaktionen Für die in-vitro Diagnostik. -20 C R-Biopharm AG, An der neuen Bergstraße 17, D-64297 Darmstadt, Germany Tel.: +49
RIDA GENE Clostridium difficile HyperTox real-time PCR Art. Nr.: PG0855 50 Reaktionen Für die in-vitro Diagnostik. -20 C R-Biopharm AG, An der neuen Bergstraße 17, D-64297 Darmstadt, Germany Tel.: +49
RIDA GENE Viral Stool Panel II real-time RT-PCR
 RIDA GENE Viral Stool Panel II realtime RTPCR Art. Nr.: PG1325 100 Reaktionen Für die invitro Diagnostik. 20 C RBiopharm AG, An der neuen Bergstraße 17, D64297 Darmstadt, Germany Tel.: +49 (0) 61 51 81
RIDA GENE Viral Stool Panel II realtime RTPCR Art. Nr.: PG1325 100 Reaktionen Für die invitro Diagnostik. 20 C RBiopharm AG, An der neuen Bergstraße 17, D64297 Darmstadt, Germany Tel.: +49 (0) 61 51 81
RIDA GENE Dientamoeba fragilis real-time PCR
 RIDA GENE Dientamoeba fragilis realtime PCR Art. Nr.: PG1745 100 Reaktionen Für die invitro Diagnostik. 20 C RBiopharm AG, An der neuen Bergstraße 17, D64297 Darmstadt, Germany Tel.: +49 (0) 61 51 81 020
RIDA GENE Dientamoeba fragilis realtime PCR Art. Nr.: PG1745 100 Reaktionen Für die invitro Diagnostik. 20 C RBiopharm AG, An der neuen Bergstraße 17, D64297 Darmstadt, Germany Tel.: +49 (0) 61 51 81 020
RIDA GENE Flu LC2.0 real-time RT-PCR
 RIDA GENE Flu LC2.0 realtime RTPCR Art. Nr.: PG0525 100 Reaktionen Für die invitro Diagnostik. 20 C RBiopharm AG, An der neuen Bergstraße 17, D64297 Darmstadt, Germany Tel.: +49 (0) 61 51 81 020 / Telefax:
RIDA GENE Flu LC2.0 realtime RTPCR Art. Nr.: PG0525 100 Reaktionen Für die invitro Diagnostik. 20 C RBiopharm AG, An der neuen Bergstraße 17, D64297 Darmstadt, Germany Tel.: +49 (0) 61 51 81 020 / Telefax:
RIDA GENE Norovirus I & II real-time RT-PCR
 RIDA GENE Norovirus I & II realtime RTPCR Art. Nr.: PG1415 100 Reaktionen Für die invitro Diagnostik. 20 C RBiopharm AG, An der neuen Bergstraße 17, D64297 Darmstadt, Germany Tel.: +49 (0) 61 51 81 020
RIDA GENE Norovirus I & II realtime RTPCR Art. Nr.: PG1415 100 Reaktionen Für die invitro Diagnostik. 20 C RBiopharm AG, An der neuen Bergstraße 17, D64297 Darmstadt, Germany Tel.: +49 (0) 61 51 81 020
RIDA GENE MRSA real-time PCR
 RIDA GENE MRSA real-time PCR Art. Nr.: PG0605 100 Reaktionen Für die in-vitro Diagnostik. -20 C R-Biopharm AG, An der neuen Bergstraße 17, D-64297 Darmstadt, Germany Tel.: +49 (0) 61 51 81 02-0 / Telefax:
RIDA GENE MRSA real-time PCR Art. Nr.: PG0605 100 Reaktionen Für die in-vitro Diagnostik. -20 C R-Biopharm AG, An der neuen Bergstraße 17, D-64297 Darmstadt, Germany Tel.: +49 (0) 61 51 81 02-0 / Telefax:
RIDA GENE Pneumocystis jirovecii real-time PCR
 RIDA GENE Pneumocystis jirovecii realtime PCR Art. Nr.: PG1905 100 Reaktionen Für die invitro Diagnostik. 20 C RBiopharm AG, An der neuen Bergstraße 17, D64297 Darmstadt, Germany Tel.: +49 (0) 61 51 81
RIDA GENE Pneumocystis jirovecii realtime PCR Art. Nr.: PG1905 100 Reaktionen Für die invitro Diagnostik. 20 C RBiopharm AG, An der neuen Bergstraße 17, D64297 Darmstadt, Germany Tel.: +49 (0) 61 51 81
MutaREAL Cytomegalovirus real time PCR Kit
 MutaREAL Cytomegalovirus real time PCR Kit Screening Test für den Nachweis von humanen Cytomegaloviren (CMV) mittels real time PCR. KV2900324 KV2900396 Nur für Forschungszwecke Immundiagnostik AG, Stubenwald-Allee
MutaREAL Cytomegalovirus real time PCR Kit Screening Test für den Nachweis von humanen Cytomegaloviren (CMV) mittels real time PCR. KV2900324 KV2900396 Nur für Forschungszwecke Immundiagnostik AG, Stubenwald-Allee
Entwicklung einer Multiplex-PCR zum Nachweis Enteropathogener Escherichia coli
 Charité-Universitätsmedizin Berlin Campus Benjamin Franklin Aus dem Institut für Infektionsmedizin Geschäftsführender Direktor Prof. Dr. med. Dr. h.c. Helmut Hahn Abteilung: Medizinische Mikrobiologie
Charité-Universitätsmedizin Berlin Campus Benjamin Franklin Aus dem Institut für Infektionsmedizin Geschäftsführender Direktor Prof. Dr. med. Dr. h.c. Helmut Hahn Abteilung: Medizinische Mikrobiologie
Bedeutung von EPEC, ETEC und EHEC. 5. Hygienetag Köln Sabine Messler
 Bedeutung von EPEC, ETEC und EHEC 5. Hygienetag Köln Sabine Messler 22.10.2014 PathogenitätsfaktorendarmpathogenerE.coli E.coli Pathovar Krankheitsbild Pathogenitätsfaktor (codierendes Gen) Enterohämorrhagische
Bedeutung von EPEC, ETEC und EHEC 5. Hygienetag Köln Sabine Messler 22.10.2014 PathogenitätsfaktorendarmpathogenerE.coli E.coli Pathovar Krankheitsbild Pathogenitätsfaktor (codierendes Gen) Enterohämorrhagische
Manual. SureFood FISH ID Gadus chalcogrammus IAAC (R&D Version) (50 Reakt.) Art. Nr. S6313. Beschreibung
 Manual Seiten 1 bis 3 Pages 4 to 6 SureFood FISH ID Gadus chalcogrammus IAAC (R&D Version) (50 Reakt.) Art. Nr. S6313 Beschreibung Mit diesem Test wird Alaska-Seelachs-DNA (Gadus chalcogrammus oder Theragra
Manual Seiten 1 bis 3 Pages 4 to 6 SureFood FISH ID Gadus chalcogrammus IAAC (R&D Version) (50 Reakt.) Art. Nr. S6313 Beschreibung Mit diesem Test wird Alaska-Seelachs-DNA (Gadus chalcogrammus oder Theragra
AdnaTest ER/PR-Detect
 PCR-Expressionsanalyse der Östrogen- und Progesteron- Hormonrezeptoren in angereicherten Tumorzellen Zur In-vitro-Diagnostik Gebrauchsanweisung T-1-532 Inhaltsverzeichnis Bestellinformation... 3 Anwendungszweck...
PCR-Expressionsanalyse der Östrogen- und Progesteron- Hormonrezeptoren in angereicherten Tumorzellen Zur In-vitro-Diagnostik Gebrauchsanweisung T-1-532 Inhaltsverzeichnis Bestellinformation... 3 Anwendungszweck...
Auswertung der Surveillance von darmpathogener Escherichia coli Hélène Englund
 Auswertung der Surveillance von darmpathogener Escherichia coli Hélène Englund [email protected] Hintergrund Escherichia coli Teil der normalen humanen Darmflora Stämme mit Virulenzfaktoren können
Auswertung der Surveillance von darmpathogener Escherichia coli Hélène Englund [email protected] Hintergrund Escherichia coli Teil der normalen humanen Darmflora Stämme mit Virulenzfaktoren können
SCRIPTUM HIGH PRECISE
 Nur für Forschungszwecke Datenblatt Artikel BS.50.020 = 20 Reaktionen x 50 µl Artikel BS.50.100 = 100 Reaktionen x 50 µl Artikel BS.50. 500 = 500 Reaktionen x 50 µl Haltbarkeit: 12 Monate Lagerung bei
Nur für Forschungszwecke Datenblatt Artikel BS.50.020 = 20 Reaktionen x 50 µl Artikel BS.50.100 = 100 Reaktionen x 50 µl Artikel BS.50. 500 = 500 Reaktionen x 50 µl Haltbarkeit: 12 Monate Lagerung bei
AdnaTest EMT-2/StemCell Add-on ProstateDetect
 AdnaTest EMT-2/StemCell Add-on ProstateDetect RT-PCR-Nachweis von Prostatakrebs-assoziierter Genexpression in angereicherten Tumorzellen Nur für Forschungszwecke Gebrauchsanweisung T-1-537-PP Inhaltsverzeichnis
AdnaTest EMT-2/StemCell Add-on ProstateDetect RT-PCR-Nachweis von Prostatakrebs-assoziierter Genexpression in angereicherten Tumorzellen Nur für Forschungszwecke Gebrauchsanweisung T-1-537-PP Inhaltsverzeichnis
RealLine DNA Extraction 2
 RealLine Pathogen Diagnostic Kits Gebrauchsinformation RealLine DNA Extraction 2 KIT FÜR DIE EXTRAKTION VON DNA AUS KLINISCHEN PROBEN In-vitro Diagnostikum RealLine DNA-Extraction 2 VBC8897 96 Tests gültig
RealLine Pathogen Diagnostic Kits Gebrauchsinformation RealLine DNA Extraction 2 KIT FÜR DIE EXTRAKTION VON DNA AUS KLINISCHEN PROBEN In-vitro Diagnostikum RealLine DNA-Extraction 2 VBC8897 96 Tests gültig
Validierung der Flüssigkulturmedien für die mikrobiologische Kontrolle gemäß Ph. Eur. 2.6.27
 Validierung der Flüssigkulturmedien für die mikrobiologische Kontrolle gemäß Ph. Eur. 2.6.27 PD Dr. Karin Janetzko Institut für Transfusionsmedizin und Immunologie DRK Blutspendedienst Baden-Württemberg
Validierung der Flüssigkulturmedien für die mikrobiologische Kontrolle gemäß Ph. Eur. 2.6.27 PD Dr. Karin Janetzko Institut für Transfusionsmedizin und Immunologie DRK Blutspendedienst Baden-Württemberg
bactotype MAP PCR Kit Gebrauchsinformation
 April 2015 bactotype MAP PCR Kit Gebrauchsinformation 24 (Katalog-Nr. 285903) 96 (Katalog-Nr. 285905) 480 (Katalog-Nr. 285907)* 1 Zum Nachweis von DNA von Mycobacterium avium subsp. paratuberculosis Die
April 2015 bactotype MAP PCR Kit Gebrauchsinformation 24 (Katalog-Nr. 285903) 96 (Katalog-Nr. 285905) 480 (Katalog-Nr. 285907)* 1 Zum Nachweis von DNA von Mycobacterium avium subsp. paratuberculosis Die
Borrelia burgdorferi s.l.
 BACTOTYPE PCR Amplification Kit Borrelia burgdorferi s.l. Labor Diagnostik Leipzig Gebrauchsanweisung Technologie Die Produktgruppe BACTOTYPE PCR Amplification Kit umfasst optimierte Systeme zum Nachweis
BACTOTYPE PCR Amplification Kit Borrelia burgdorferi s.l. Labor Diagnostik Leipzig Gebrauchsanweisung Technologie Die Produktgruppe BACTOTYPE PCR Amplification Kit umfasst optimierte Systeme zum Nachweis
Mycobacterium paratuberculosis
 BACTOTYPE PCR Amplification Kit Mycobacterium paratuberculosis Labor Diagnostik Leipzig Gebrauchsanweisung Technologie Die Produktgruppe BACTOTYPE PCR Amplification Kit umfasst optimierte Systeme zum Nachweis
BACTOTYPE PCR Amplification Kit Mycobacterium paratuberculosis Labor Diagnostik Leipzig Gebrauchsanweisung Technologie Die Produktgruppe BACTOTYPE PCR Amplification Kit umfasst optimierte Systeme zum Nachweis
Genisolierung in 2 Stunden : Die Polymerase-Ketten-Reaktion (PCR)
 PCR Genisolierung in 2 Stunden : Die Polymerase-Ketten-Reaktion (PCR) von Kary B. Mullis entwickelt (1985) eigentlich im Mai 1983 bei einer nächtlichen Autofahrt erstes erfolgreiches Experiment am 16.12.1983
PCR Genisolierung in 2 Stunden : Die Polymerase-Ketten-Reaktion (PCR) von Kary B. Mullis entwickelt (1985) eigentlich im Mai 1983 bei einer nächtlichen Autofahrt erstes erfolgreiches Experiment am 16.12.1983
Entwicklung und Validierung der VIROTYPE BVDV real-time RT-PCR
 Entwicklung und Validierung der real-time RT-PCR Gaunitz C, Engemann C, Labitzke M, Schroeder C, Kühn TE, Gabert, J Labor Diagnostik GmbH Leipzig Gliederung Testprinzip Testprotokoll Testcharakteristik
Entwicklung und Validierung der real-time RT-PCR Gaunitz C, Engemann C, Labitzke M, Schroeder C, Kühn TE, Gabert, J Labor Diagnostik GmbH Leipzig Gliederung Testprinzip Testprotokoll Testcharakteristik
Mycoplasma gallisepticum
 BACTOTYPE PCR Amplification Kit Mycoplasma gallisepticum Labor Diagnostik Leipzig Gebrauchsanweisung Technologie Die Produktgruppe BACTOTYPE PCR Amplification Kit umfasst optimierte Systeme zum Nachweis
BACTOTYPE PCR Amplification Kit Mycoplasma gallisepticum Labor Diagnostik Leipzig Gebrauchsanweisung Technologie Die Produktgruppe BACTOTYPE PCR Amplification Kit umfasst optimierte Systeme zum Nachweis
DIE ZEIT IST REIF- IMPFEN GEGEN DIE ÖDEMKRANKHEIT
 DIE ZEIT IST REIF- IMPFEN GEGEN DIE ÖDEMKRANKHEIT Schweinetag Sachsen-Anhalt Iden 28.10.2014 Dr. Kathrin Lillie-Jaschniski IDT Biologika GmbH Gliederung Diagnose Prophylaxe/Therapie Feldstudien Zusammenfassung
DIE ZEIT IST REIF- IMPFEN GEGEN DIE ÖDEMKRANKHEIT Schweinetag Sachsen-Anhalt Iden 28.10.2014 Dr. Kathrin Lillie-Jaschniski IDT Biologika GmbH Gliederung Diagnose Prophylaxe/Therapie Feldstudien Zusammenfassung
RIDA GENE Pneumocystis jirovecii
 Klinische Diagnostik November 2012 2013 Titelthema RIDA GENE Pneumocystis jirovecii Neu! Mit der RIDA GENE Pneumocystis jirovecii real-time PCR führt die R-Biopharm AG ihren ersten quantitativen real-time
Klinische Diagnostik November 2012 2013 Titelthema RIDA GENE Pneumocystis jirovecii Neu! Mit der RIDA GENE Pneumocystis jirovecii real-time PCR führt die R-Biopharm AG ihren ersten quantitativen real-time
Chlamydia sp. BACTOTYPE PCR Amplification Kit. Gebrauchsanweisung. Labor Diagnostik Leipzig
 BACTOTYPE PCR Amplification Kit Chlamydia sp. Labor Diagnostik Leipzig Gebrauchsanweisung Technologie Die Produktgruppe BACTOTYPE PCR Amplification Kit umfasst optimierte Systeme zum Nachweis von pathogenen
BACTOTYPE PCR Amplification Kit Chlamydia sp. Labor Diagnostik Leipzig Gebrauchsanweisung Technologie Die Produktgruppe BACTOTYPE PCR Amplification Kit umfasst optimierte Systeme zum Nachweis von pathogenen
Informationsveranstaltung Heimtierfuttermittel. PCR-Analytik zur Bestimmung von GVOs in Heimtierfuttermitteln. C. Haldemann, ALP
 Informationsveranstaltung Heimtierfuttermittel PCR-Analytik zur Bestimmung von GVOs in Heimtierfuttermitteln C. Haldemann, ALP Grundidee des Nachweises von GVOs mittels PCR Die Bestimmung genveränderter
Informationsveranstaltung Heimtierfuttermittel PCR-Analytik zur Bestimmung von GVOs in Heimtierfuttermitteln C. Haldemann, ALP Grundidee des Nachweises von GVOs mittels PCR Die Bestimmung genveränderter
diarellapanlegionella real time PCR Kit LC
 Gebrauchsinformation diarellapanlegionella real time PCR Kit LC Für den in vitro Nachweis von Legionella spezies in klinischem Probenmaterial bei gleichzeitiger Differenzierung von L. pneumophila. G01019-32
Gebrauchsinformation diarellapanlegionella real time PCR Kit LC Für den in vitro Nachweis von Legionella spezies in klinischem Probenmaterial bei gleichzeitiger Differenzierung von L. pneumophila. G01019-32
1. Einleitung Stand der Forschung Enteropathogene E. coli. 1. Einleitung
 1. Einleitung Escherichia coli (E. coli) ist der häufigste Erreger bakterieller Infektionen beim Menschen. Fakultativ pathogene Stämme von E. coli sind Bestandteil der physiologischen Darmflora. Sie können
1. Einleitung Escherichia coli (E. coli) ist der häufigste Erreger bakterieller Infektionen beim Menschen. Fakultativ pathogene Stämme von E. coli sind Bestandteil der physiologischen Darmflora. Sie können
Infektiöse Gastroenteritis
 Infektiöse Gastroenteritis Epidemiologie der Gastroenteritis Eine der häufigsten Ursachen für Morbidität und Mortalität der Weltbevölkerung 5 Mio. Kinder versterben jährlich an Diarrhoe 1997 in Deutschland
Infektiöse Gastroenteritis Epidemiologie der Gastroenteritis Eine der häufigsten Ursachen für Morbidität und Mortalität der Weltbevölkerung 5 Mio. Kinder versterben jährlich an Diarrhoe 1997 in Deutschland
ZytoFast DNA (+) Control Probe
 ZytoFast DNA (+) Control Probe (Digoxigenin-markiert) T-1053-400 40 (0,4 ml) Zum Nachweis humaner repetitiver Alu-Sequenzen durch chromogene in situ Hybridisierung (CISH).... In-Vitro-Diagnostikum gemäß
ZytoFast DNA (+) Control Probe (Digoxigenin-markiert) T-1053-400 40 (0,4 ml) Zum Nachweis humaner repetitiver Alu-Sequenzen durch chromogene in situ Hybridisierung (CISH).... In-Vitro-Diagnostikum gemäß
MutaPLATE Enterovirus real time RT-PCR Kit (TaqMan)
 MutaPLATE Enterovirus real time RT-PCR Kit (TaqMan) Qualitativer Test für den spezifischen Nachweis von humanen Enteroviren (Polio-, Coxsackie A-, Coxsackie B- und Echoviren) in real time PCR - Mikrotiterplattensystemen
MutaPLATE Enterovirus real time RT-PCR Kit (TaqMan) Qualitativer Test für den spezifischen Nachweis von humanen Enteroviren (Polio-, Coxsackie A-, Coxsackie B- und Echoviren) in real time PCR - Mikrotiterplattensystemen
Gebrauchsanleitung ChromoQuant QF-PCR Kit P/N 412.001-48
 Gebrauchsanleitung ChromoQuant QF-PCR Kit P/N 412.001-48 ChromoQuant Das ChromoQuant in vitro Diagnose-Set QF-PCR 1 zur Analyse von häufigen chromosomalen Erkrankungen der Chromosomen 13, 18 und 21 412.001-48u
Gebrauchsanleitung ChromoQuant QF-PCR Kit P/N 412.001-48 ChromoQuant Das ChromoQuant in vitro Diagnose-Set QF-PCR 1 zur Analyse von häufigen chromosomalen Erkrankungen der Chromosomen 13, 18 und 21 412.001-48u
Enteritis infectiosa Stand April 2009
 UniversitätsKlinikum Heidelberg Ihre Krankenhaushygiene informiert Enteritis infectiosa Das vorliegende Merkblatt enthält in ausführlicher schriftlicher Form die wichtigsten Empfehlungen zu Hygienemaßnahmen
UniversitätsKlinikum Heidelberg Ihre Krankenhaushygiene informiert Enteritis infectiosa Das vorliegende Merkblatt enthält in ausführlicher schriftlicher Form die wichtigsten Empfehlungen zu Hygienemaßnahmen
IfSGMeldeVO. Verordnung
 Verordnung des Sächsischen Staatsministeriums für Soziales und Verbraucherschutz über die Erweiterung der Meldepflicht für übertragbare Krankheiten und Krankheitserreger nach dem Infektionsschutzgesetz
Verordnung des Sächsischen Staatsministeriums für Soziales und Verbraucherschutz über die Erweiterung der Meldepflicht für übertragbare Krankheiten und Krankheitserreger nach dem Infektionsschutzgesetz
Protokoll Praktikum für Humanbiologie Studenten
 Protokoll Praktikum für Humanbiologie Studenten Teil A: Charakterisierung der Auswirkungen von γ Interferon auf die Protein und mrna Mengen in humanen A549 Lungenepithelzellen. Studentenaufgaben Tag 1
Protokoll Praktikum für Humanbiologie Studenten Teil A: Charakterisierung der Auswirkungen von γ Interferon auf die Protein und mrna Mengen in humanen A549 Lungenepithelzellen. Studentenaufgaben Tag 1
bis zu 71% der Patienten, die C. diff im Krankenhaus erwerben, entwickeln eine symptomatische CDAD Die weiteren Themen:
 Klinische Diagnostik Oktober Juni/2007 2010 Titelthema ein Nosokomialkeim von großer Relevanz weiter auf Seite 2 bis zu 71% der Patienten, die C. diff im Krankenhaus erwerben, entwickeln eine symptomatische
Klinische Diagnostik Oktober Juni/2007 2010 Titelthema ein Nosokomialkeim von großer Relevanz weiter auf Seite 2 bis zu 71% der Patienten, die C. diff im Krankenhaus erwerben, entwickeln eine symptomatische
4. Diskussion Sensitivität und Spezifität. 4. Diskussion
 4. Diskussion Obwohl enteropathogene E. coli bis zu 30% aller Durchfälle weltweit (1) auslösen, stellt der auf kulturellen Verfahren basierende Nachweis ein großes Problem dar. Somit liegen, mit Ausnahme
4. Diskussion Obwohl enteropathogene E. coli bis zu 30% aller Durchfälle weltweit (1) auslösen, stellt der auf kulturellen Verfahren basierende Nachweis ein großes Problem dar. Somit liegen, mit Ausnahme
Leistungsverzeichnis
 Institut für Hygiene Ostmerheimer Straße 200 51109 Köln Leistungsverzeichnis Köln, den 23. März 2016 Inhaltsverzeichnis Nachweis von Methicillin-resistenten S.aureus (MRSA)... 4 Kultureller Nachweis...
Institut für Hygiene Ostmerheimer Straße 200 51109 Köln Leistungsverzeichnis Köln, den 23. März 2016 Inhaltsverzeichnis Nachweis von Methicillin-resistenten S.aureus (MRSA)... 4 Kultureller Nachweis...
RIDASCREEN Echinococcus IgG
 RIDASCREEN Echinococcus IgG Art. No.: K7621 R-Biopharm AG, An der neuen Bergstraße 17, D-64297 Darmstadt, Germany Tel.: +49 6151 8102-0 / Telefax: +49 6151 8102-20 1. Anwendungsbereich Für die in vitro
RIDASCREEN Echinococcus IgG Art. No.: K7621 R-Biopharm AG, An der neuen Bergstraße 17, D-64297 Darmstadt, Germany Tel.: +49 6151 8102-0 / Telefax: +49 6151 8102-20 1. Anwendungsbereich Für die in vitro
Dr. habil. Anna Salek. Vorteile Serotypisierung Legionella: Falsch negatives oder positives Ergebnis
 Dr. habil. Anna Salek Vorteile Serotypisierung Legionella: Falsch negatives oder positives Ergebnis Was ist in Ihrer Wasserleitung? Legionellen: Regelmäßige Kontrollen Regelmäßige Kontrollen sind unverzichtbar
Dr. habil. Anna Salek Vorteile Serotypisierung Legionella: Falsch negatives oder positives Ergebnis Was ist in Ihrer Wasserleitung? Legionellen: Regelmäßige Kontrollen Regelmäßige Kontrollen sind unverzichtbar
RIDA QUICK Legionella
 RIDA QUICK Legionella Art. No.: N8003 R-Biopharm AG, An der neuen Bergstraße 17, D-64297 Darmstadt, Germany Tel.: +49 (0) 61 51 81 02-0 / Telefax: +49 (0) 61 51 81 02-20 C 1. Anwendungsbereich Für die
RIDA QUICK Legionella Art. No.: N8003 R-Biopharm AG, An der neuen Bergstraße 17, D-64297 Darmstadt, Germany Tel.: +49 (0) 61 51 81 02-0 / Telefax: +49 (0) 61 51 81 02-20 C 1. Anwendungsbereich Für die
Etablierung einer. Homemade - PCR
 Etablierung einer Homemade - PCR Anja Schöpflin Institut für Pathologie Universitätsklinikum Freiburg Überblick: Anwendungsgebiete der PCR Anforderungen an Primer Auswahl geeigneter Primer / Primerdesign
Etablierung einer Homemade - PCR Anja Schöpflin Institut für Pathologie Universitätsklinikum Freiburg Überblick: Anwendungsgebiete der PCR Anforderungen an Primer Auswahl geeigneter Primer / Primerdesign
DiversiLab TM Schnelle und reproduzierbare Stammtypisierung
 DIVERSILABTM DiversiLab TM Schnelle und reproduzierbare Stammtypisierung 2/24 Weshalb Stammtypisierung? Eine Stammtypisierung dient nicht zur Identifizierung eines Erregers sondern um abzuklären, ob zwei
DIVERSILABTM DiversiLab TM Schnelle und reproduzierbare Stammtypisierung 2/24 Weshalb Stammtypisierung? Eine Stammtypisierung dient nicht zur Identifizierung eines Erregers sondern um abzuklären, ob zwei
AdnaTest ColonCancerDetect
 AdnaTest ColonCancerDetect RT-PCR-Nachweis von Darmkrebs-assoziierter Genexpression in angereicherten Tumorzellen Zur In-vitro-Diagnostik Gebrauchsanweisung T-1-505 Inhaltsverzeichnis Bestellinformation...
AdnaTest ColonCancerDetect RT-PCR-Nachweis von Darmkrebs-assoziierter Genexpression in angereicherten Tumorzellen Zur In-vitro-Diagnostik Gebrauchsanweisung T-1-505 Inhaltsverzeichnis Bestellinformation...
Schnelle EHEC-Diagnostik direkt aus Stuhl
 Schnelle EHEC-Diagnostik direkt aus Stuhl D. Orth, K. Grif, N. Leichtfried, R. Würzner Österreichisches Referenzzentrum für EHEC Department für Hygiene, Mikrobiologie und Sozialmedizin Medizinische Universität
Schnelle EHEC-Diagnostik direkt aus Stuhl D. Orth, K. Grif, N. Leichtfried, R. Würzner Österreichisches Referenzzentrum für EHEC Department für Hygiene, Mikrobiologie und Sozialmedizin Medizinische Universität
Ergebnisse Praktikum-Mikrobiologie Mikrobiologische Wasseruntersuchungen
Ergebnisse Praktikum-Mikrobiologie Mikrobiologische Wasseruntersuchungen Gruppe Bestimmung der Koloniezahl (Versuch Nr. 13) Koloniezahl (KBE/mL) nach 2, 3 und 4 Tagen bei 22 C Koloniezahl (KBE/mL) nach
Ergebnisse Praktikum-Mikrobiologie Mikrobiologische Wasseruntersuchungen Gruppe Bestimmung der Koloniezahl (Versuch Nr. 13) Koloniezahl (KBE/mL) nach 2, 3 und 4 Tagen bei 22 C Koloniezahl (KBE/mL) nach
Entwicklung und Validierung von multiplex real-time RT-PCR assays in der Virusdiagnostik
 Entwicklung und Validierung von multiplex real-time RT-PCR assays in der Virusdiagnostik Bernd Hoffmann, Klaus R. Depner, Horst Schirrmeier & Martin Beer Friedrich-Loeffler-Institut Greifswald-Insel Riems
Entwicklung und Validierung von multiplex real-time RT-PCR assays in der Virusdiagnostik Bernd Hoffmann, Klaus R. Depner, Horst Schirrmeier & Martin Beer Friedrich-Loeffler-Institut Greifswald-Insel Riems
ZytoFast HPV High-Risk (HR) Types Probe (Digoxigenin
 ZytoFast HPV High-Risk (HR) Types Probe (Digoxigenin Digoxigenin-markiert markiert) T-1140-400 40 (0,4 ml) Zum Nachweis von Human Papilloma Virus (HPV) Typ 16/18/31/33/35/39/45/51/52/56/58/59/66/68/82
ZytoFast HPV High-Risk (HR) Types Probe (Digoxigenin Digoxigenin-markiert markiert) T-1140-400 40 (0,4 ml) Zum Nachweis von Human Papilloma Virus (HPV) Typ 16/18/31/33/35/39/45/51/52/56/58/59/66/68/82
Fortschritte in der Diagnostik häufiger Infektionskrankheiten. Ursula Flückiger Zentrum Innere Medizin Hirslanden Klinik Aarau
 Fortschritte in der Diagnostik häufiger Infektionskrankheiten Ursula Flückiger Zentrum Innere Medizin Hirslanden Klinik Aarau Themen Maldi TOF: Identifikation von Bakterien Durchfall, Pneumonie Mulitplex
Fortschritte in der Diagnostik häufiger Infektionskrankheiten Ursula Flückiger Zentrum Innere Medizin Hirslanden Klinik Aarau Themen Maldi TOF: Identifikation von Bakterien Durchfall, Pneumonie Mulitplex
3 Reaktionen für Kontrollen (1x Negativkontrolle und 2x Positive Control)
 Manual Seiten 1 bis 4 Pages 5 to 8 SureFood GMO QUANT 35S Soya (2 x 50 Reakt.) Art. Nr. S2028 Beschreibung Dieser Test dient der relativen quantitativen Abschätzung des 35S CaMV Promotor DNA-Anteils in
Manual Seiten 1 bis 4 Pages 5 to 8 SureFood GMO QUANT 35S Soya (2 x 50 Reakt.) Art. Nr. S2028 Beschreibung Dieser Test dient der relativen quantitativen Abschätzung des 35S CaMV Promotor DNA-Anteils in
Untersuchungen zum mikrobiologischen Risikopotenzial von Gärsubstraten und Gärresten aus niedersächsischen Biogasanlagen
 Untersuchungen zum mikrobiologischen Risikopotenzial von Gärsubstraten und Gärresten aus niedersächsischen Biogasanlagen Gerhard Breves, Physiologisches Institut Gliederung 1.Einleitung 2.Studiendesign
Untersuchungen zum mikrobiologischen Risikopotenzial von Gärsubstraten und Gärresten aus niedersächsischen Biogasanlagen Gerhard Breves, Physiologisches Institut Gliederung 1.Einleitung 2.Studiendesign
TrueScience RespiFinder Identification Panels
 TrueScience RespiFinder Identification Panels KURZANLEITUNG Die Richtlinien zur Sicherheit und Biogefährdung finden Sie im Abschnitt Safety im TrueScience RespiFinder Identification Panels Protocol (PN
TrueScience RespiFinder Identification Panels KURZANLEITUNG Die Richtlinien zur Sicherheit und Biogefährdung finden Sie im Abschnitt Safety im TrueScience RespiFinder Identification Panels Protocol (PN
Anlage zur Akkreditierungsurkunde D ML 19288 01 00
 Deutsche Akkreditierungsstelle GmbH Anlage zur Akkreditierungsurkunde D ML 19288 01 00 nach DIN EN ISO 15189:2014 Gültigkeitsdauer: 11.12.2014 bis 10.12.2019 Ausstellungsdatum: 11.12.2014 Urkundeninhaber:
Deutsche Akkreditierungsstelle GmbH Anlage zur Akkreditierungsurkunde D ML 19288 01 00 nach DIN EN ISO 15189:2014 Gültigkeitsdauer: 11.12.2014 bis 10.12.2019 Ausstellungsdatum: 11.12.2014 Urkundeninhaber:
Bakterielle Kontamination in humanen Stammzell-Präparaten Einfluss von Stammzellquellen und Hygienevorgaben. W. Schwarz Paul-Ehrlich-Institut Langen
 Bundesinstitut für Impfstoffe und biomedizinische Arzneimittel www.pei.de Bakterielle Kontamination in humanen Stammzell-Präparaten Einfluss von W. Schwarz Paul-Ehrlich-Institut Langen Methoden bzw. Matrix-Validierung
Bundesinstitut für Impfstoffe und biomedizinische Arzneimittel www.pei.de Bakterielle Kontamination in humanen Stammzell-Präparaten Einfluss von W. Schwarz Paul-Ehrlich-Institut Langen Methoden bzw. Matrix-Validierung
Gastroenteritis Gastrointestinale Infektionen
 Infektiöse Gastroenteritis Gastrointestinale Infektionen OA Dr. M. Kutilek Zentralklinikum St. Pölten Laut WHO Schätzungen leiden jährlich 900 Mio.Menschen an infektiösen Durchfallserkrankungen 8 15 Mio
Infektiöse Gastroenteritis Gastrointestinale Infektionen OA Dr. M. Kutilek Zentralklinikum St. Pölten Laut WHO Schätzungen leiden jährlich 900 Mio.Menschen an infektiösen Durchfallserkrankungen 8 15 Mio
Mikrobiologische Diagnostik- wann ist was sinnvoll?
 Mikrobiologische Diagnostik- wann ist was sinnvoll? Radiologisch-internistisches Forum 09.07.2008 C. Ott Enge Assoziation von Infektionen mit CED fragliche pathogenetische Bedeutung von M. paratuberculosis
Mikrobiologische Diagnostik- wann ist was sinnvoll? Radiologisch-internistisches Forum 09.07.2008 C. Ott Enge Assoziation von Infektionen mit CED fragliche pathogenetische Bedeutung von M. paratuberculosis
MutaPLATE Norovirus real time RT-PCR Kit
 MutaPLATE Norovirus real time RT-PCR Kit Qualitativer Test für den spezifischen Nachweis von Noroviren (Genogruppe I und II) in offenen (z.b. Mikrotiterplattenformat) real time PCR - Systemen (z. B. von
MutaPLATE Norovirus real time RT-PCR Kit Qualitativer Test für den spezifischen Nachweis von Noroviren (Genogruppe I und II) in offenen (z.b. Mikrotiterplattenformat) real time PCR - Systemen (z. B. von
Zeitaufgelöste Fluoreszenzmessung zur Verwendung bei der Realtime-PCR
 Zeitaufgelöste Fluoreszenzmessung zur Verwendung bei der Realtime-PCR Nils Scharke, inano Abstract Die Verwendung neuartiger Seltenerd-Komplexe in Verbindung mit zeitaufgelöster Fluoreszenzmessung liefert
Zeitaufgelöste Fluoreszenzmessung zur Verwendung bei der Realtime-PCR Nils Scharke, inano Abstract Die Verwendung neuartiger Seltenerd-Komplexe in Verbindung mit zeitaufgelöster Fluoreszenzmessung liefert
Optimierung der Testkit-Verpackungen
 Klinische Diagnostik November Juni 2012 2013 Titelthema Optimierung der Testkit-Verpackungen Barcode, Originalverschlüsse, Etiketten-Layout R-Biopharm führt folgende Optimierungen der Testkit-Verpackungen
Klinische Diagnostik November Juni 2012 2013 Titelthema Optimierung der Testkit-Verpackungen Barcode, Originalverschlüsse, Etiketten-Layout R-Biopharm führt folgende Optimierungen der Testkit-Verpackungen
RIDASCREEN Clostridium perfringens Enterotoxin
 RIDASCREEN Clostridium perfringens Enterotoxin Art. No.: C0601 R-Biopharm AG, An der neuen Bergstraße 17, D-64297 Darmstadt, Germany Tel.: +49 (0) 61 51 81 02-0 / Telefax: +49 (0) 61 51 81 02-20 1. Anwendungsbereich
RIDASCREEN Clostridium perfringens Enterotoxin Art. No.: C0601 R-Biopharm AG, An der neuen Bergstraße 17, D-64297 Darmstadt, Germany Tel.: +49 (0) 61 51 81 02-0 / Telefax: +49 (0) 61 51 81 02-20 1. Anwendungsbereich
Real-Time PCR Methoden Lebensmittelanalytik. Schneller, Einfacher, Besser
 Real-Time PCR Methoden Lebensmittelanalytik Schneller, Einfacher, Besser Das iq-check System macht sich alle Vorteile der Real-Time PCR zu Nutzen, um schnellere und zuverlässige Lösungen für die Untersuchung
Real-Time PCR Methoden Lebensmittelanalytik Schneller, Einfacher, Besser Das iq-check System macht sich alle Vorteile der Real-Time PCR zu Nutzen, um schnellere und zuverlässige Lösungen für die Untersuchung
zur Differentialdiagnose bei Rheuma
 Molekulare l Analyse von HLA B27 zur Differentialdiagnose bei Rheuma Dr. Maria Haß Seminar Molekulare Diagnostik 2014 Bio Products, Wien HLA System Humanes Leukozytenantigen, = Haupthistokompatibilitätskomplex
Molekulare l Analyse von HLA B27 zur Differentialdiagnose bei Rheuma Dr. Maria Haß Seminar Molekulare Diagnostik 2014 Bio Products, Wien HLA System Humanes Leukozytenantigen, = Haupthistokompatibilitätskomplex
BAVMAP Bayernweites Monitoring von Antibiotikaresistenzen
 BAVMAP Bayernweites Monitoring von Antibiotikaresistenzen Bayerisches Staatsministerium für Umwelt und Gesundheit Historisches Murray-Kollektion klinische Isolate aus präantibiotischer Zeit (1917-1954)
BAVMAP Bayernweites Monitoring von Antibiotikaresistenzen Bayerisches Staatsministerium für Umwelt und Gesundheit Historisches Murray-Kollektion klinische Isolate aus präantibiotischer Zeit (1917-1954)
Screening auf darmpathogene Erreger
 Screening auf darmpathogene Erreger 4. Kölner Hygienetag 20.01.2014 Dr. S. Flommersfeld Folie 1 Es besteht kein Interessenkonflikt! 20.01.2014 Dr. S. Flommersfeld Folie 2 Relevanz: RKI Abfrage 2003 2012
Screening auf darmpathogene Erreger 4. Kölner Hygienetag 20.01.2014 Dr. S. Flommersfeld Folie 1 Es besteht kein Interessenkonflikt! 20.01.2014 Dr. S. Flommersfeld Folie 2 Relevanz: RKI Abfrage 2003 2012
Produktkatalog 2010. Molekularbiologische Reagenzien
 Produktion, Vertrieb und Serviceleistung im Bereich der Molekularbiologie und Medizin Produktkatalog 2010 Molekularbiologische Reagenzien Molegene GmbH Bienenweg 28 35764 Sinn Tel. 02772-570952 Fax 02772-570945
Produktion, Vertrieb und Serviceleistung im Bereich der Molekularbiologie und Medizin Produktkatalog 2010 Molekularbiologische Reagenzien Molegene GmbH Bienenweg 28 35764 Sinn Tel. 02772-570952 Fax 02772-570945
Klebsiella oxytoca als Ursache der hämorrhagischen
 Klebsiella oxytoca als Ursache der hämorrhagischen Antibiotikacolitis a.o. Univ. Prof. Dr. Christoph Högenauer, Abteilung für Gastroenterologie und Hepatologie, Universitätsklinik für Innere Medizin Graz.
Klebsiella oxytoca als Ursache der hämorrhagischen Antibiotikacolitis a.o. Univ. Prof. Dr. Christoph Högenauer, Abteilung für Gastroenterologie und Hepatologie, Universitätsklinik für Innere Medizin Graz.
3 GFP green fluorescent protein
 SCHNUPPERKURS GENTECHNIK 1 ExploHeidelberg 2 Klonierung des Phagen Lambda 3 GFP green fluorescent protein 4 Gens in a bottle Vanessa Hecht 1 ExploHeidelberg Stiftung Jugend und Wissenschaft GmbH Technologiepark
SCHNUPPERKURS GENTECHNIK 1 ExploHeidelberg 2 Klonierung des Phagen Lambda 3 GFP green fluorescent protein 4 Gens in a bottle Vanessa Hecht 1 ExploHeidelberg Stiftung Jugend und Wissenschaft GmbH Technologiepark
HPV DNA-Chip. PapilloCheck HPV-Screening. DNA-Chip für die Identifizierung von 24 humanen Papillomavirus Typen
 HPV DNA-Chip PapilloCheck HPV-Screening DNA-Chip für die Identifizierung von 24 humanen Papillomavirus Typen PapilloCheck : schnell und zuverlässig PapilloCheck im Überblick Komplettes Kit mit DNA-Arrays
HPV DNA-Chip PapilloCheck HPV-Screening DNA-Chip für die Identifizierung von 24 humanen Papillomavirus Typen PapilloCheck : schnell und zuverlässig PapilloCheck im Überblick Komplettes Kit mit DNA-Arrays
Reagenzien Isolierung von Nukleinsäuren
 Aufbewahrung bei Raumtemperatur Anwendung Isolierung ultrareiner Plasmid-DNA aus Bakterienkulturen von 1 ml bis 800 ml. Die Plasmid-DNA eignet sich für Manuelle und automatisierte Sequenzierung mit Fluoreszenzfarbstoffen
Aufbewahrung bei Raumtemperatur Anwendung Isolierung ultrareiner Plasmid-DNA aus Bakterienkulturen von 1 ml bis 800 ml. Die Plasmid-DNA eignet sich für Manuelle und automatisierte Sequenzierung mit Fluoreszenzfarbstoffen
DDT Bauchschmerz Akute Diarrhoe
 DDT Bauchschmerz Akute Diarrhoe Prof. Dr. med. Ursula Seidler Klinik für Gastroenterologie, Hepatologie, und Endokrinologie Ärztl. Direktor: Prof. Dr. med. M. P. Manns Das Problem In entwickelten Ländern
DDT Bauchschmerz Akute Diarrhoe Prof. Dr. med. Ursula Seidler Klinik für Gastroenterologie, Hepatologie, und Endokrinologie Ärztl. Direktor: Prof. Dr. med. M. P. Manns Das Problem In entwickelten Ländern
Einsatz einer Rinder-spezifischen Internen Kontrolle im Rahmen des BVDV-Nachweises mittels real-time RT-PCR aus Ohrgewebe
 Bayerisches Landesamt für Gesundheit und Lebensmittelsicherheit Einsatz einer Rinder-spezifischen Internen Kontrolle im Rahmen des BVDV-Nachweises mittels real-time RT-PCR aus Ohrgewebe AVID-Workshop BVD-Ohrstanzendiagnostik
Bayerisches Landesamt für Gesundheit und Lebensmittelsicherheit Einsatz einer Rinder-spezifischen Internen Kontrolle im Rahmen des BVDV-Nachweises mittels real-time RT-PCR aus Ohrgewebe AVID-Workshop BVD-Ohrstanzendiagnostik
Rolle von Multiplex PCR Tests in der ambulanten Diagnostik
 Klinik für Infektionskrankheiten, 22. Symposium «Infektionskrankheiten in der Praxis», 3. Dezember, Zürich Rolle von Multiplex PCR Tests in der ambulanten Diagnostik Roberto Speck, MD Multiplex PCR erlaubt
Klinik für Infektionskrankheiten, 22. Symposium «Infektionskrankheiten in der Praxis», 3. Dezember, Zürich Rolle von Multiplex PCR Tests in der ambulanten Diagnostik Roberto Speck, MD Multiplex PCR erlaubt
Antimikrobiell wirksame Kupferbasiswerkstoffe zusätzlicher Baustein zur Reduktion von Infektionsrisiken. www.diehl.com/diehlmetall
 Antimikrobiell wirksame Kupferbasiswerkstoffe zusätzlicher Baustein zur Reduktion von Infektionsrisiken www.diehl.com/diehlmetall Status Quo In Deutschland erkranken jährlich ca. 400.000 bis 600.000 Patientinnen
Antimikrobiell wirksame Kupferbasiswerkstoffe zusätzlicher Baustein zur Reduktion von Infektionsrisiken www.diehl.com/diehlmetall Status Quo In Deutschland erkranken jährlich ca. 400.000 bis 600.000 Patientinnen
Gebrauchsinformation. Neospora-p38 ELISA Cattle
 Gebrauchsinformation Neospora-p38 ELISA Cattle Test zum Nachweis von IgG-Antikörpern gegen den Erreger Neospora caninum bei Rindern In-vitro Diagnostikum für Tiere Bestandteile des Kits: 1 Mikrotiterplatte,
Gebrauchsinformation Neospora-p38 ELISA Cattle Test zum Nachweis von IgG-Antikörpern gegen den Erreger Neospora caninum bei Rindern In-vitro Diagnostikum für Tiere Bestandteile des Kits: 1 Mikrotiterplatte,
Kapillarelektrophorese DNA-Sequenzierung
 Kapillarelektrophorese DNA-Sequenzierung DNA Kettenanalyse oder DNA-Sequenzierung wird bei der Anordnung der Primärstruktur und Bestimmung der Nukleotid-Basensequenz verwendet. Die Analyse basiert auf
Kapillarelektrophorese DNA-Sequenzierung DNA Kettenanalyse oder DNA-Sequenzierung wird bei der Anordnung der Primärstruktur und Bestimmung der Nukleotid-Basensequenz verwendet. Die Analyse basiert auf
cobas T HSV 1/2 Test Erweiterung Ihres STI Menüs mit Dual-Target Detektion für zuverlässige Befunde
 cobas T HSV 1/2 Test Erweiterung Ihres STI Menüs mit Dual-Target Detektion für zuverlässige Befunde Zuverlässige HSV 1/2 Ergebnisse, zukunftssicher Herpes simplex Viren zählen zu den am häufigsten sexuell
cobas T HSV 1/2 Test Erweiterung Ihres STI Menüs mit Dual-Target Detektion für zuverlässige Befunde Zuverlässige HSV 1/2 Ergebnisse, zukunftssicher Herpes simplex Viren zählen zu den am häufigsten sexuell
Erstellt vom Unterausschuss Methodenentwicklung der LAG, März 2006 Status: verabschiedet
 Methodensammlung der Bund/Länder-Arbeitsgemeinschaft Gentechnik (LAG) Real-Time PCR zur quantitativen Bestimmung gentechnisch veränderter Rapslinien mit dem 35S/pat-Genkonstrukt Erstellt vom Unterausschuss
Methodensammlung der Bund/Länder-Arbeitsgemeinschaft Gentechnik (LAG) Real-Time PCR zur quantitativen Bestimmung gentechnisch veränderter Rapslinien mit dem 35S/pat-Genkonstrukt Erstellt vom Unterausschuss
Neue diagnostische Verfahren zum Nachweis von Erregern Lebensmittelbedingter Infektionen
 FEDERAL INSTITUTE FOR RISK ASSESSMENT Neue diagnostische Verfahren zum Nachweis von Erregern Lebensmittelbedingter Infektionen Burkhard Malorny Moderne Erregerdiagnostik: Der Wettlauf gegen die Zeit Ziel:
FEDERAL INSTITUTE FOR RISK ASSESSMENT Neue diagnostische Verfahren zum Nachweis von Erregern Lebensmittelbedingter Infektionen Burkhard Malorny Moderne Erregerdiagnostik: Der Wettlauf gegen die Zeit Ziel:
Trinkwasser und Lebensmittelhygiene Heike von Baum Med. Mikrobiologie und Hygiene 500-65350 [email protected]
 Trinkwasser und Lebensmittelhygiene Heike von Baum Med. Mikrobiologie und Hygiene 500-65350 [email protected] Lernziele Maßgaben der Trinkwasserverordnung Legionellen Prinzipien der Lebensmittelhygiene
Trinkwasser und Lebensmittelhygiene Heike von Baum Med. Mikrobiologie und Hygiene 500-65350 [email protected] Lernziele Maßgaben der Trinkwasserverordnung Legionellen Prinzipien der Lebensmittelhygiene
Plasmidisolierung. Mit Plasmiden können Sie Gene in Organismen einschleusen und so deren Eigenschaften verändern.
 Plasmidisolierung Mit Plasmiden können Sie Gene in Organismen einschleusen und so deren Eigenschaften verändern. Was können Sie lernen? Sie lernen eine ringförmige DNA, ein Plasmid, zu isolieren. Mit diesem
Plasmidisolierung Mit Plasmiden können Sie Gene in Organismen einschleusen und so deren Eigenschaften verändern. Was können Sie lernen? Sie lernen eine ringförmige DNA, ein Plasmid, zu isolieren. Mit diesem
qep: Anwendung im Detail
 Nachweis von Mykoplasmen mit Venor GeM-qEP qep: Anwendung im Detail Information der Biochrom AG Venor GeM-qEP ist ein Nukleinsäure-Amplifikationstest für den in vitro-nachweis von Mykoplasmen. Venor GeM-qEP
Nachweis von Mykoplasmen mit Venor GeM-qEP qep: Anwendung im Detail Information der Biochrom AG Venor GeM-qEP ist ein Nukleinsäure-Amplifikationstest für den in vitro-nachweis von Mykoplasmen. Venor GeM-qEP
PFBV - ELISA. Enzyme Linked Immuno Sorbent Assay. zum Nachweis des. Pelargonium flower break virus (PFBV)
 Baumgartenstr. 5 D-79285 Ebringen (FRG) Tel.: +49 7664 600254 Fax: +49 7664 600255 Email: [email protected] PFBV - ELISA Enzyme Linked Immuno Sorbent Assay zum Nachweis des Pelargonium flower break
Baumgartenstr. 5 D-79285 Ebringen (FRG) Tel.: +49 7664 600254 Fax: +49 7664 600255 Email: [email protected] PFBV - ELISA Enzyme Linked Immuno Sorbent Assay zum Nachweis des Pelargonium flower break
Zink Transporter 8 (ZnT8) Ab ELISA
 Arbeitsanleitung Zink Transporter 8 (ZnT8) Ab ELISA Enzymimmunoassay für die quantitative Bestimmung von ZnT8-Autoantikörpern in Serum I V D REF EA102/96 12 x 8 2 8 C DLD Gesellschaft für Diagnostika und
Arbeitsanleitung Zink Transporter 8 (ZnT8) Ab ELISA Enzymimmunoassay für die quantitative Bestimmung von ZnT8-Autoantikörpern in Serum I V D REF EA102/96 12 x 8 2 8 C DLD Gesellschaft für Diagnostika und
Gerhard Breves Physiologisches Institut
 Untersuchungen zur Mikrobiologie, zu Arzneimittelrückständen und multiresistenten Mikroorganismen in Biogasanlagen unter besonderer Berücksichtigung von Hühnertrockenkot als Gärsubstrat Gerhard Breves
Untersuchungen zur Mikrobiologie, zu Arzneimittelrückständen und multiresistenten Mikroorganismen in Biogasanlagen unter besonderer Berücksichtigung von Hühnertrockenkot als Gärsubstrat Gerhard Breves
Anlage zur Akkreditierungsurkunde D-PL-17456-01-00 nach DIN EN ISO/IEC 17025:2005
 Deutsche Akkreditierungsstelle GmbH Anlage zur Akkreditierungsurkunde D-PL-17456-01-00 nach DIN EN ISO/IEC 17025:2005 Gültigkeitsdauer: 21.08.2014 bis 20.08.2019 Ausstellungsdatum: 21.08.2014 Urkundeninhaber:
Deutsche Akkreditierungsstelle GmbH Anlage zur Akkreditierungsurkunde D-PL-17456-01-00 nach DIN EN ISO/IEC 17025:2005 Gültigkeitsdauer: 21.08.2014 bis 20.08.2019 Ausstellungsdatum: 21.08.2014 Urkundeninhaber:
MutaPLEX Norovirus real time RT-PCR Kit
 MutaPLEX Norovirus real time RT-PCR Kit Qualitativer Test für den spezifischen Nachweis von Noroviren (GG I, II) in offenen (z.b. Mikrotiterplattenformat) real time PCR - Systemen (z. B. von Applied Biosystems,
MutaPLEX Norovirus real time RT-PCR Kit Qualitativer Test für den spezifischen Nachweis von Noroviren (GG I, II) in offenen (z.b. Mikrotiterplattenformat) real time PCR - Systemen (z. B. von Applied Biosystems,
SingleQuant Assay Kit
 GEBRAUCHSANLEITUNG SingleQuant Assay Kit Kit für die Proteinkonzentrationsbestimmung (Kat.-Nr. 39226) SERVA Electrophoresis GmbH Carl-Benz-Str. 7 D-69115 Heidelberg Phone +49-6221-138400, Fax +49-6221-1384010
GEBRAUCHSANLEITUNG SingleQuant Assay Kit Kit für die Proteinkonzentrationsbestimmung (Kat.-Nr. 39226) SERVA Electrophoresis GmbH Carl-Benz-Str. 7 D-69115 Heidelberg Phone +49-6221-138400, Fax +49-6221-1384010
Der Familie der Enterobacteriaceae werden u.a. folgende pathogene, gelegentlich pathogene und apathogene Stäbchen-Bakterien zugeordnet:
 METHODEN ZUM NACHWEIS VON COLIFORMEN / E. COLI Beziehungen zwischen Enterobacteriaceen, Coliformen, Fäkalcoliformen und : Der Familie der Enterobacteriaceae werden u.a. folgende pathogene, gelegentlich
METHODEN ZUM NACHWEIS VON COLIFORMEN / E. COLI Beziehungen zwischen Enterobacteriaceen, Coliformen, Fäkalcoliformen und : Der Familie der Enterobacteriaceae werden u.a. folgende pathogene, gelegentlich
WESAMIN GmbH & Co. KG
 WESAMIN GmbH & Co. KG Arbeitsanleitung Histamin - Lebensmittel ELISA Enzymimmunoassay für die quantitative Bestimmung von Histamin in Wein, Fischmehl, Fisch, Wurst, Käse und Milch REF HLM00 96 2 8 C WESAMIN
WESAMIN GmbH & Co. KG Arbeitsanleitung Histamin - Lebensmittel ELISA Enzymimmunoassay für die quantitative Bestimmung von Histamin in Wein, Fischmehl, Fisch, Wurst, Käse und Milch REF HLM00 96 2 8 C WESAMIN
